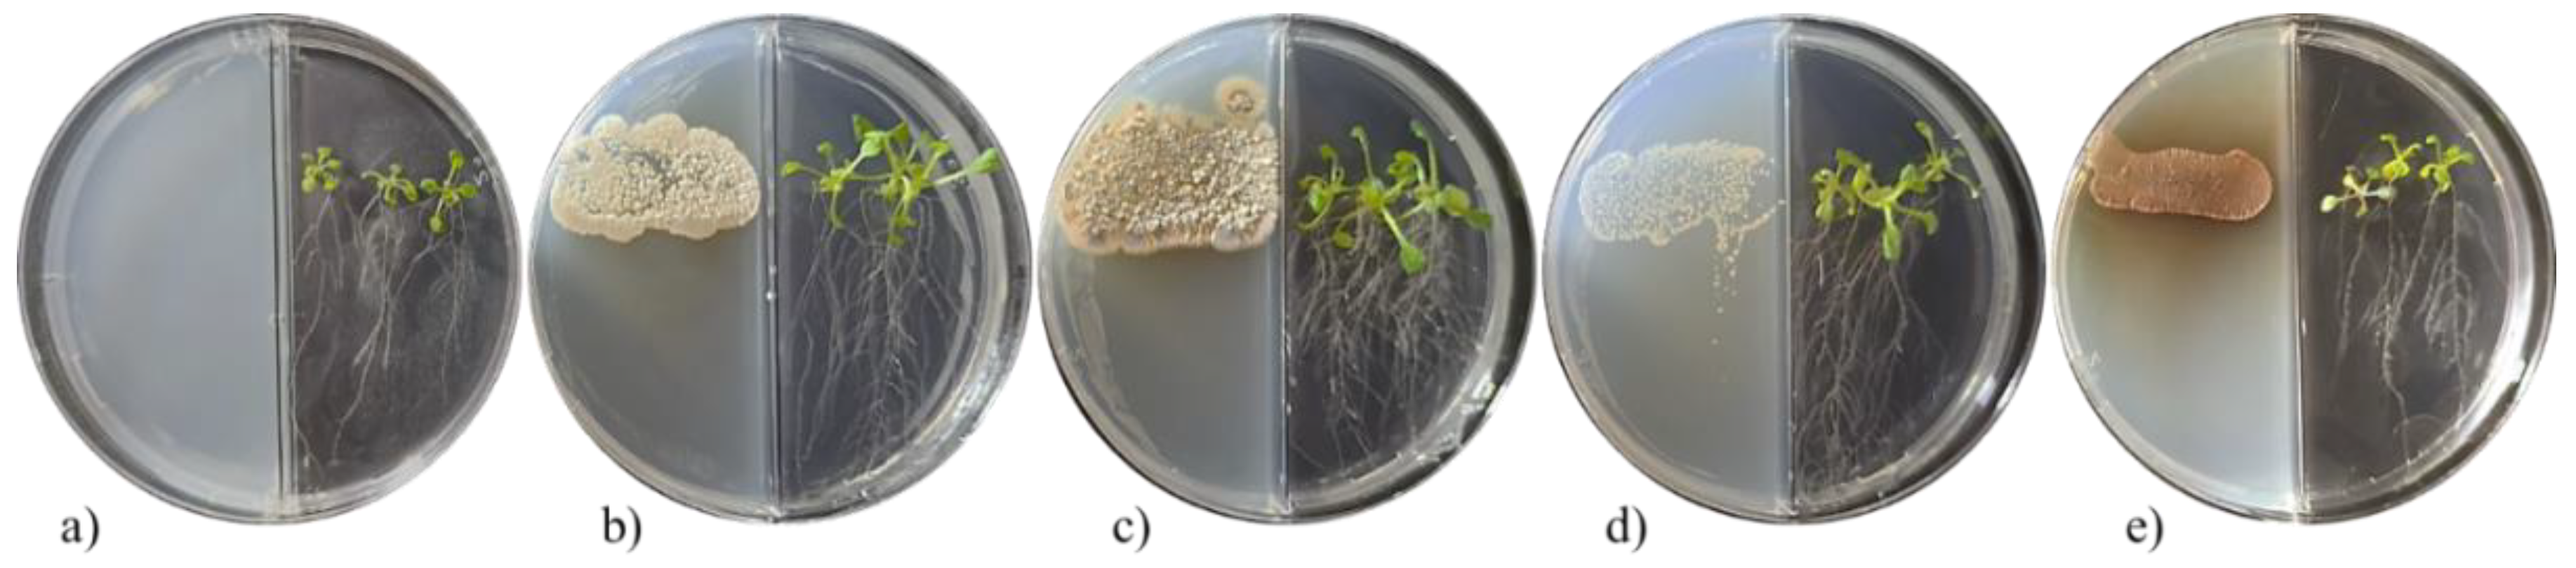
Plants 11 00875 g001 550
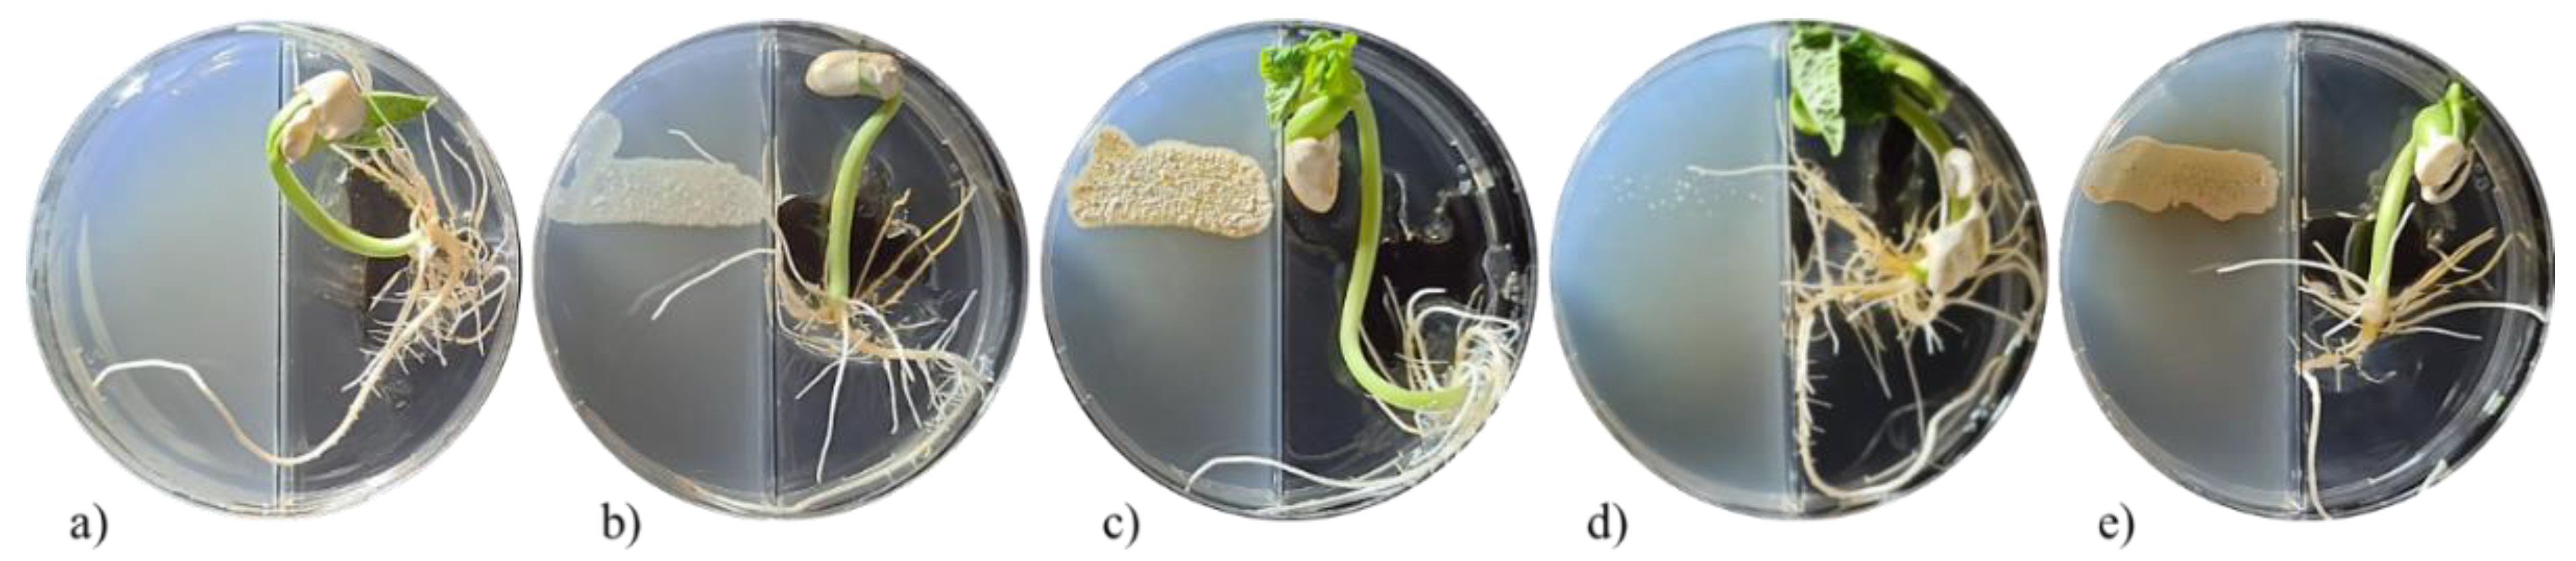
Plants 11 00875 g003 550

Growth Promotion of Phaseolus vulgaris and Arabidopsis thaliana Seedlings by Streptomycetes Volatile Compounds
Abstract
:1. Introduction
2. Results
2.1. Phytohormone Production and Solubilization of P and Fixation of N by Streptomyces Strains
2.2. In Vitro Plant-Growth-Promoting Activity of Streptomyces VOCs in A. thaliana and P. vulgaris Seedlings
2.3. In Situ Effect of Streptomyces on Growth of Bean Seedlings
2.4. In Vitro Growth Promotion of A. thaliana Seedlings by Pure VOCs
3. Discussion
4. Material and Methods
4.1. Reagents and Microorganism Strains and Seeds
4.2. Evaluation of the Nitrogen Fixing and Phosphate Solubilization Activities of Streptomyces Strains
4.3. Indole-3-Acetic Acid (IAA) and Siderophore Production
4.4. In Vitro Growth Promotion of Arabidopsis thaliana by Streptomyces VOCs
4.5. In Vitro and In Situ Growth Promotion of P. vulgaris by Streptomyces VOCs
4.6. In Vitro Growth Promotion of Arabidopsis thaliana Seedlings by Pure VOCs
4.7. Statistical Analysis
5. Conclusions
Author Contributions
Funding
Data Availability Statement
Acknowledgments
Conflicts of Interest
References
- Gupta, G.; Parihar, S.S.; Ahirwar, N.K.; Snehi, S.K.; Singh, V. Plant growth promoting rhizobacteria (PGPR): Current and future prospects for development of sustainable agriculture. J. Microb. Biochem. Technol. 2015, 7, 96–102. [Google Scholar] [CrossRef]
- Kunova, A.; Bonaldi, M.; Saracchi, M.; Pizzatti, C.; Chen, X.; Cortesi, P. Selection of Streptomyces against soil borne fungal pathogens by a standardized dual culture assay and evaluation of their effects on seed germination and plant growth. BMC Microbiol. 2016, 16, 272. [Google Scholar] [CrossRef] [PubMed] [Green Version]
- Mahanty, T.; Bhattacharjee, S.; Goswami, M.; Bhattacharyya, P.; Das, B.; Ghosh, A.; Tribedi, P. Biofertilizers: A potential approach for sustainable agriculture development. Environ. Sci. Pollut. Res. Int. 2017, 24, 3315–3335. [Google Scholar] [CrossRef] [PubMed]
- Vejan, P.; Abdullah, R.; Khadiran, T.; Ismail, S.; Nasrulhaq Boyce, A. Role of plant growth promoting rhizobacteria in agricultural sustainability—A review. Molecules 2016, 21, 573. [Google Scholar] [CrossRef]
- Bargaz, A.; Lyamlouli, K.; Chtouki, M.; Zeroual, Y.; Dhiba, D. Soil microbial resources for improving fertilizers efficiency in an integrated plant nutrient management system. Front. Microbiol. 2018, 9, 1606. [Google Scholar] [CrossRef] [Green Version]
- Noumavo, P.A.; Agbodjato, N.A.; Baba-Moussa, F.; Adjanohoun, A.; Baba-Moussa, L. Plant growth promoting rhizobacteria: Beneficial effects for healthy and sustainable agriculture. Afr. J. Biotechnol. 2016, 15, 1452–1463. [Google Scholar] [CrossRef] [Green Version]
- Saeed, Q.; Xiukang, W.; Haider, F.U.; Kučerik, J.; Mumtaz, M.Z.; Holatko, J.; Naseem, M.; Kintl, A.; Ejaz, M.; Naveed, M. Rhizosphere Bacteria in Plant Growth Promotion, Biocontrol, and Bioremediation of Contaminated Sites: A Comprehensive Review of Effects and Mechanisms. Int. J. Mol. Sci. 2021, 22, 10529. [Google Scholar] [CrossRef] [PubMed]
- Alka, S.; Shahir, S.; Ibrahim, N.; Chai, T.-T.; Bahari, Z.M.; Abd Manan, F. The role of plant growth promoting bacteria on arsenic removal: A review of existing perspectives. Environ. Technol. Innov. 2020, 17, 100602. [Google Scholar] [CrossRef]
- Harir, M.; Bendif, H.; Bellahcene, M.; Fortas, Z.; Pogni, R. Streptomyces secondary metabolites. Basic Biol. Appl. Actinobacteria 2018, 6, 99–122. [Google Scholar] [CrossRef] [Green Version]
- de Jesus Sousa, J.A.; Olivares, F.L. Plant growth promotion by streptomycetes: Ecophysiology, mechanisms and applications. Chem. Biol. Technol. Agric. 2016, 3, 24. [Google Scholar] [CrossRef] [Green Version]
- Dias, M.P.; Bastos, M.S.; Xavier, V.B.; Cassel, E.; Astarita, L.V.; Santarém, E.R. Plant growth and resistance promoted by Streptomyces spp. in tomato. Plant Physiol. Biochem. 2017, 118, 479–493. [Google Scholar] [CrossRef] [PubMed]
- Dede, A.; Güven, K.; Şahin, N. Isolation, plant growth-promoting traits, antagonistic effects on clinical and plant pathogenic organisms and identification of actinomycetes from olive rhizosphere. Microb. Pathog. 2020, 143, 104134. [Google Scholar] [CrossRef] [PubMed]
- Pérez-Corral, D.A.; de Jesús Ornelas Paz, J.; Olivas-Orozco, G.I.; Acosta-Muñiz, C.H.; Salas-Marina, M.Á.; Ruiz-Cisneros, M.F.; Molina-Corral, F.J.; Fernández-Pavía, S.P.; Rios-Velasco, C. Antagonistic effect of volatile and non-volatile compounds from Streptomyces strains on cultures of several phytopathogenic fungi. Emir. J. Food Agric. 2020, 32, 879–889. [Google Scholar] [CrossRef]
- Boukaew, S.; Plubrukam, A.; Prasertsan, P. Effect of volatile substances from Streptomyces philanthi RM-1-138 on growth of Rhizoctonia solani on rice leaf. BioControl 2013, 58, 471–482. [Google Scholar] [CrossRef]
- Wan, M.; Li, G.; Zhang, J.; Jiang, D.; Huang, H.-C. Effect of volatile substances of Streptomyces platensis F-1 on control of plant fungal diseases. Biol. Control 2008, 46, 552–559. [Google Scholar] [CrossRef]
- Ma, W.; Zhao, L.; Zhao, W.; Xie, Y. €-2-Hexenal, as a potential natural antifungal compound, inhibits Aspergillus flavus spore germination by disrupting mitochondrial energy metabolism. J. Agric. Food Chem. 2019, 67, 1138–1145. [Google Scholar] [CrossRef]
- Yang, M.; Lu, L.; Pang, J.; Hu, Y.; Guo, Q.; Li, Z.; Wu, S.; Liu, H.; Wang, C. Biocontrol activity of volatile organic compounds from Streptomyces alboflavus TD-1 against Aspergillus flavus growth and aflatoxin production. J. Microbiol. 2019, 57, 396–404. [Google Scholar] [CrossRef]
- Zhang, J.; Tian, H.; Sun, H.; Wang, X. Antifungal activity of trans-2-hexenal against Penicillium cyclopium by a membrane damage mechanism. J. Food Biochem. 2017, 41, e12289. [Google Scholar] [CrossRef]
- Wonglom, P.; Ito, S.-I.; Sunpapao, A. Volatile organic compounds emitted from endophytic fungus Trichoderma asperellum T1 mediate antifungal activity, defense response and promote plant growth in lettuce (Lactuca sativa). Fungal Ecol. 2020, 43, 100867. [Google Scholar] [CrossRef]
- Tahir, H.A.; Gu, Q.; Wu, H.; Raza, W.; Hanif, A.; Wu, L.; Colman, M.V.; Gao, X. Plant growth promotion by volatile organic compounds produced by Bacillus subtilis SYST2. Front. Microbiol. 2017, 8, 171. [Google Scholar] [CrossRef] [Green Version]
- Matse, D.T.; Huang, C.-H.; Huang, Y.-M.; Yen, M.-Y. Effects of coinoculation of Rhizobium with plant growth promoting rhizobacteria on the nitrogen fixation and nutrient uptake of Trifolium repens in low phosphorus soil. J. Plant Nutr. 2020, 43, 739–752. [Google Scholar] [CrossRef]
- Ryu, M.-H.; Zhang, J.; Toth, T.; Khokhani, D.; Geddes, B.A.; Mus, F.; Garcia-Costas, A.; Peters, J.W.; Poole, P.S.; Ané, J.-M. Control of nitrogen fixation in bacteria that associate with cereals. Nat. Microbiol. 2020, 5, 314–330. [Google Scholar] [CrossRef]
- Mazumdar, D.; Saha, S.P.; Ghosh, S. Isolation, screening and application of a potent PGPR for enhancing growth of Chickpea as affected by nitrogen level. Int. J. Veg. Sci. 2020, 26, 333–350. [Google Scholar] [CrossRef]
- Chouyia, F.E.; Romano, I.; Fechtali, T.; Fagnano, M.; Fiorentino, N.; Visconti, D.; Idbella, M.; Ventorino, V.; Pepe, O. P-Solubilizing Streptomyces roseocinereus MS1B15 with multiple plant growth-promoting traits enhance barley development and regulate rhizosphere microbial population. Front. Plant Sci. 2020, 11, 1137. [Google Scholar] [CrossRef]
- Verma, V.; Singh, S.; Prakash, S. Bio-control and plant growth promotion potential of siderophore producing endophytic Streptomyces from Azadirachta indica A. Juss. J. Basic Microbiol. 2011, 51, 550–556. [Google Scholar] [CrossRef] [PubMed]
- Jog, R.; Pandya, M.; Nareshkumar, G.; Rajkumar, S. Mechanism of phosphate solubilization and antifungal activity of Streptomyces spp. isolated from wheat roots and rhizosphere and their application in improving plant growth. Microbiology 2014, 160, 778–788. [Google Scholar] [CrossRef] [Green Version]
- Dahal, B.; NandaKafle, G.; Perkins, L.; Brözel, V.S. Diversity of free-Living nitrogen fixing Streptomyces in soils of the badlands of South Dakota. Microbiol. Res. 2017, 195, 31–39. [Google Scholar] [CrossRef]
- Gaby, J.C.; Buckley, D.H. A comprehensive evaluation of PCR primers to amplify the nifH gene of nitrogenase. PLoS ONE 2012, 7, e42149. [Google Scholar] [CrossRef] [Green Version]
- Olanrewaju, O.S.; Babalola, O.O. Streptomyces: Implications and interactions in plant growth promotion. Appl. Microbiol. Biotechnol. 2019, 103, 1179–1188. [Google Scholar] [CrossRef] [Green Version]
- Khamna, S.; Yokota, A.; Lumyong, S. Actinomycetes isolated from medicinal plant rhizosphere soils: Diversity and screening of antifungal compounds, indole-3-acetic acid and siderophore production. World J. Microbiol. Biotechnol. 2009, 25, 649–655. [Google Scholar] [CrossRef]
- Keswani, C.; Singh, S.P.; Cueto, L.; García-Estrada, C.; Mezaache-Aichour, S.; Glare, T.R.; Borriss, R.; Singh, S.P.; Blázquez, M.A.; Sansinenea, E. Auxins of microbial origin and their use in agriculture. Appl. Microbiol. Biotechnol. 2020, 104, 8549–8565. [Google Scholar] [CrossRef] [PubMed]
- Ashraf, M.A.; Rasool, M.; Mirza, M.S. Nitrogen fixation and indole acetic acid production potential of bacteria isolated from rhizosphere of sugarcane (Saccharum officinarum L.). Adv. Biol. Res. 2011, 5, 348–355. [Google Scholar]
- Cordovez, V.; Carrion, V.J.; Etalo, D.W.; Mumm, R.; Zhu, H.; Van Wezel, G.P.; Raaijmakers, J.M. Diversity and functions of volatile organic compounds produced by Streptomyces from a disease-suppressive soil. Front. Microbiol. 2015, 6, 1081. [Google Scholar] [CrossRef] [PubMed] [Green Version]
- Farag, M.A.; Ryu, C.-M.; Sumner, L.W.; Paré, P.W. GC–MS SPME profiling of rhizobacterial volatiles reveals prospective inducers of growth promotion and induced systemic resistance in plants. Phytochemistry 2006, 67, 2262–2268. [Google Scholar] [CrossRef] [PubMed]
- Pérez-Flores, P.; Valencia-Cantero, E.; Altamirano-Hernández, J.; Pelagio-Flores, R.; López-Bucio, J.; García-Juárez, P.; Macías-Rodríguez, L. Bacillus methylotrophicus M4-96 isolated from maize (Zea mays) rhizoplane increases growth and auxin content in Arabidopsis thaliana via emission of volatiles. Protoplasma 2017, 254, 2201–2213. [Google Scholar] [CrossRef] [PubMed]
- Lee, S.; Yap, M.; Behringer, G.; Hung, R.; Bennett, J.W. Volatile organic compounds emitted by Trichoderma species mediate plant growth. Fungal Biol. Biotechnol. 2016, 3, 7. [Google Scholar] [CrossRef] [Green Version]
- Jana, G.A.; Yaish, M.W. Isolation and functional characterization of a mVOC producing plant-growth-promoting bacterium isolated from the date palm rhizosphere. Rhizosphere 2020, 16, 100267. [Google Scholar] [CrossRef]
- Schulz-Bohm, K.; Martín-Sánchez, L.; Garbeva, P. Microbial volatiles: Small molecules with an important role in intra-and inter-kingdom interactions. Front. Microbiol. 2017, 8, 2484. [Google Scholar] [CrossRef]
- El-Tarabily, K.A.; Sivasithamparam, K. Non-streptomycete actinomycetes as biocontrol agents of soil-borne fungal plant pathogens and as plant growth promoters. Soil Biol. Biochem. 2006, 38, 1505–1520. [Google Scholar] [CrossRef]
- Sadeghi, A.; Karimi, E.; Dahaji, P.A.; Javid, M.G.; Dalvand, Y.; Askari, H. Plant growth promoting activity of an auxin and siderophore producing isolate of Streptomyces under saline soil conditions. World J. Microbiol. Biotechnol. 2012, 28, 1503–1509. [Google Scholar] [CrossRef]
- AlAli, H.A.; Khalifa, A.; Al-Malki, M. Plant growth-promoting rhizobacteria from Ocimum basilicum improve growth of Phaseolus vulgaris and Abelmoschus esculentus. S. Afr. J. Bot. 2021, 139, 200–209. [Google Scholar] [CrossRef]
- Kumari, P.; Meena, M.; Gupta, P.; Dubey, M.K.; Nath, G.; Upadhyay, R. Plant growth promoting rhizobacteria and their biopriming for growth promotion in mung bean (Vigna radiata (L.) R. Wilczek). Biocatal. Agric. Biotechnol. 2018, 16, 163–171. [Google Scholar] [CrossRef]
- Karnwal, A. Isolation and identification of plant growth promoting rhizobacteria from maize (Zea mays L.) rhizosphere and their plant growth promoting effect on rice (Oryza sativa L.). J. Plant Prot. Res. 2017, 57, 144–151. [Google Scholar] [CrossRef]
- Gopalakrishnan, S.; Srinivas, V.; Vidya, M.S.; Rathore, A. Plant growth-promoting activities of Streptomyces spp. in sorghum and rice. SpringerPlus 2013, 2, 574. [Google Scholar] [CrossRef] [Green Version]
- Tyagi, S.; Kim, K.; Cho, M.; Lee, K.J. Volatile dimethyl disulfide affects root system architecture of Arabidopsis via modulation of canonical auxin signaling pathways. Environ. Sustain. 2019, 2, 211–216. [Google Scholar] [CrossRef]
- Plyuta, V.; Chernikova, A.; Sidorova, D.; Kupriyanova, E.; Koksharova, O.; Chernin, L.; Khmel, I. Modulation of Arabidopsis thaliana growth by volatile substances emitted by Pseudomonas and Serratia strains. World J. Microbiol. Biotechnol. 2021, 37, 82. [Google Scholar] [CrossRef] [PubMed]
- Gamboa-Becerra, R.; Desgarennes, D.; Molina-Torres, J.; Ramírez-Chávez, E.; Kiel-Martínez, A.L.; Carrión, G.; Ortiz-Castro, R. Plant growth-promoting and non-promoting rhizobacteria from avocado trees differentially emit volatiles that influence growth of Arabidopsis thaliana. Protoplasma 2021, 1–20. [Google Scholar] [CrossRef]
- Pérez-Corral, D.A.; García-González, N.Y.; Gallegos-Morales, G.; Ruiz-Cisneros, M.F.; Berlanga-Reyes, D.I.; Ríos-Velasco, C. Aislamiento de actinomicetos asociados a rizosfera de árboles de manzano antagónicos a Fusarium equiseti. Rev. Mex. Cienc. Agric. 2015, 6, 1629–1638. [Google Scholar]
- Ahmad, B.; Nigar, S.; Malik, N.A.; Bashir, S.; Ali, J.; Yousaf, S.; Bangash, J.A.; Jan, I. Isolation and characterization of cellulolytic nitrogen fixing Azotobacter species from wheat rhizosphere of Khyber Pakhtunkhwa. World Appl. Sci. J. 2013, 27, 51–60. [Google Scholar] [CrossRef]
- Nautiyal, C.S. An efficient microbiological growth medium for screening phosphate solubilizing microorganisms. FEMS Microbiol. Lett. 1999, 170, 265–270. [Google Scholar] [CrossRef]
- Shirling, E.T.; Gottlieb, D. Methods for characterization of Streptomyces species. Int. J. Syst. Evol. Microbiol. 1966, 16, 313–340. [Google Scholar] [CrossRef] [Green Version]
- de Oliveira-Longatti, S.M.; Marra, L.M.; Soares, B.L.; Bomfeti, C.A.; Da Silva, K.; Ferreira, P.A.A.; de Souza Moreira, F.M. Bacteria isolated from soils of the western Amazon and from rehabilitated bauxite-mining areas have potential as plant growth promoters. World J. Microbiol. Biotechnol. 2014, 30, 1239–1250. [Google Scholar] [CrossRef] [PubMed]
- Schwyn, B.; Neilands, J. Universal chemical assay for the detection and determination of siderophores. Anal. Biochem. 1987, 160, 47–56. [Google Scholar] [CrossRef]
- Lee, J.; Postmaster, A.; Soon, H.P.; Keast, D.; Carson, K.C. Siderophore production by actinomycetes isolates from two soil sites in Western Australia. Biometals 2012, 25, 285–296. [Google Scholar] [CrossRef]
- Amaresan, N.; Jayakumar, V.; Kumar, K.; Thajuddin, N. Isolation and characterization of plant growth promoting endophytic bacteria and their effect on tomato (Lycopersicon esculentum) and chilli (Capsicum annuum) seedling growth. Ann. Microbiol. 2012, 62, 805–810. [Google Scholar] [CrossRef]

| Strains | Plant Growth Promotion Tests | |||||
|---|---|---|---|---|---|---|
| Indole-3-Acetic Acid Production (mg/L) * | Siderophores | Nitrogen Fixing Activity | Phosphate Solubilization Activity | |||
| Trihydroxamate | Dihydroxamate | Catechol | ||||
| S. cangkringensis CIAD-CA07 | 77.5 ± 15.0 a | + | − | − | − | + |
| S. misionensis CIAD-CA27 | 37.5 ± 5.0 b | + | − | − | − | + |
| S. kanamyceticus CIAD-CA45 | 17.5 ± 15.0 bc | + | − | − | − | + |
| S. kanamyceticus CIAD-CA48 | 10.0 ± 0.0 c | + | − | − | − | + |
Publisher’s Note: MDPI stays neutral with regard to jurisdictional claims in published maps and institutional affiliations. |
© 2022 by the authors. Licensee MDPI, Basel, Switzerland. This article is an open access article distributed under the terms and conditions of the Creative Commons Attribution (CC BY) license (https://creativecommons.org/licenses/by/4.0/).
Share and Cite
Pérez-Corral, D.A.; Ornelas-Paz, J.d.J.; Olivas, G.I.; Acosta-Muñiz, C.H.; Salas-Marina, M.Á.; Berlanga-Reyes, D.I.; Sepulveda, D.R.; Mares-Ponce de León, Y.; Rios-Velasco, C. Growth Promotion of Phaseolus vulgaris and Arabidopsis thaliana Seedlings by Streptomycetes Volatile Compounds. Plants 2022, 11, 875. https://doi.org/10.3390/plants11070875
Pérez-Corral DA, Ornelas-Paz JdJ, Olivas GI, Acosta-Muñiz CH, Salas-Marina MÁ, Berlanga-Reyes DI, Sepulveda DR, Mares-Ponce de León Y, Rios-Velasco C. Growth Promotion of Phaseolus vulgaris and Arabidopsis thaliana Seedlings by Streptomycetes Volatile Compounds. Plants. 2022; 11(7):875. https://doi.org/10.3390/plants11070875
Chicago/Turabian StylePérez-Corral, Daniel Alonso, José de Jesús Ornelas-Paz, Guadalupe Isela Olivas, Carlos Horacio Acosta-Muñiz, Miguel Ángel Salas-Marina, David Ignacio Berlanga-Reyes, David Roberto Sepulveda, Yericka Mares-Ponce de León, and Claudio Rios-Velasco. 2022. "Growth Promotion of Phaseolus vulgaris and Arabidopsis thaliana Seedlings by Streptomycetes Volatile Compounds" Plants 11, no. 7: 875. https://doi.org/10.3390/plants11070875
APA StylePérez-Corral, D. A., Ornelas-Paz, J. d. J., Olivas, G. I., Acosta-Muñiz, C. H., Salas-Marina, M. Á., Berlanga-Reyes, D. I., Sepulveda, D. R., Mares-Ponce de León, Y., & Rios-Velasco, C. (2022). Growth Promotion of Phaseolus vulgaris and Arabidopsis thaliana Seedlings by Streptomycetes Volatile Compounds. Plants, 11(7), 875. https://doi.org/10.3390/plants11070875

